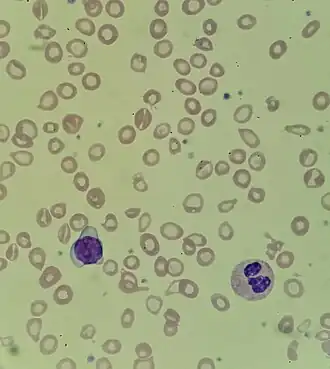

Anemia hipocrómica
| Anemia hipocrómica | ||
|---|---|---|
Frotis de sangre de una anemia microcítica hipocroma. Nótese la palidez central de los hematíes | ||
| Especialidad | hematología | |
La anemia hipocrómica (del griego υπο 'bajo' y χρoμα 'color'), también conocida como la enfermedad verde, es un tipo de anemia que se caracteriza porque los glóbulos rojos tienen menos color de lo normal al examinarlos bajo un microscopio. Esto generalmente ocurre cuando no hay suficiente cantidad del pigmento que transporta el oxígeno (hemoglobina) en dichos glóbulos rojos.[1] La causa más común de hipocromía es la insuficiencia de hierro en el cuerpo (deficiencia de hierro). Si no se trata, puede llevar a un trastorno llamado anemia ferropénica.
Clínicamente, el color puede evaluarse mediante la hemoglobina corpuscular media (MCH) o concentración media de hemoglobina corpuscular (MCHC).[2] El MCHC se considera el mejor parámetro de los dos, ya que se ajusta al efecto que tiene el tamaño de la célula sobre la cantidad de hemoglobina. La hipocromía se define clínicamente como por debajo del rango de referencia normal de MCH de 27 a 33 picogramos / célula en adultos o por debajo del rango de referencia normal de MCHC de 33 a 36 g / dL en adultos
Causas
Las causas más comunes asociadas con este tipo de anemia incluyen la talasemia, anemia ferropénica y anemia sideroblástica, aunque existen muchas otras causas asociadas con esta condición:[3]
- La deficiencia de vitamina B6 es responsable de la baja ingesta de hierro o asociada a una absorción reducida del mineral.
- Las enfermedades infecciosas parasitarias, como anquilostomas.
- El envenenamiento por plomo.
- Las úlceras estomacales o hemorragias causadas por hemorroides.
- Los trastornos congénitos del desarrollo.
Síntomas
Algunos de los síntomas más notables son:[4]
- La debilidad, la irritabilidad, el cansancio y la fatiga son síntomas comunes asociados con esta afección.
- La piel pálida o ictericia (coloración amarilla de la piel), la caída del cabello y uñas frágiles.
- El aumento de la frecuencia cardiaca o taquicardia junto con dificultades respiratorias.
- Dolor en la boca, estreñimiento, etc. también se puede observar en casos de anemia hipocrómica grave.
- La incapacidad para concentrarse con dolores de cabeza frecuentes es uno de los síntomas más característicos
- La frecuencia cardíaca aumenta a más de 100 latidos por minuto
- Las irregularidades menstruales, las infecciones frecuentes y el frío de la mano y los pies son otros síntomas comunes asociados con esta enfermedad
- La pica se observa comúnmente en individuos con anemia hipocrómica. Pica se caracteriza por el anhelo extremo de artículos no alimentarios como suciedad, papel y pintura. La pica se considera a menudo como un signo guía de la deficiencia de hierro en el cuerpo
Diagnóstico
Para establecer la razón del estado hipocrómico, se sugieren las siguientes pruebas:[3][5][6]
- Ferritina sérica (con este estudio se mide el nivel de hierro en la sangre)
- Evaluación de las reservas de hierro de la médula ósea (puede valorarse la presencia de gránulos de hierro dentro de los normoblastos)
- Capacidad de fijación de hierro (El hierro se moviliza a través de la sangre adherido a una proteína llamada transferrina. Este examen le ayuda a su proveedor de atención médica a saber qué tan bien puede esa proteína transportar el hierro en la sangre)
Tratamiento
El tratamiento depende de la causa de la enfermedad. Los médicos suelen recomendar la toma de suplementos de hierro y vitamina B6. Otros posibles tratamientos incluyen:[7]
- Antibióticos para tratar infecciones crónicas causantes de anemia.
- Hormonas para controlar periodos menstruales con sangrado irregularmente vasto (Progeterona).[8]
- Medicamento para estimular la producción de glóbulos rojos.
- Transfusiones de sangre.
- Cirugía para corregir úlceras estomacales con sangrado o tumores en las vísceras.
- Quelación, en caso de que la condición se presente debido a una intoxicación por plomo (saturnismo).
Prevención
La mejor manera de prevenir la anemia hipocrómica es por medio de la modificación de la dieta:[9]
- Tomar alimentos ricos en hierro para evitar la deficiencia de este en nuestro organismo
- Subir nuestra ingesta de alimentos que contengan vitamina C para que el cuerpo absorba de mejor manera el hierro
- Si por alguna razón estos no ayudan, se recomienda tomar suplementas tanto de vitamina C como de hierro, siempre después de que lo diagnostique un médico.
Alimentos ricos en hierro
- Carne roja.
- Carne avícola.
- Vegetales de hoja oscura tales como acelga y espinaca.
- Aproximadamente 3.5 onzas (100 gramos) de espinacas crudas contienen 2.7 mg de hierro, o el 15% de la DV[10]
- Pulsos como frijoles y frijoles rojos.
- Frutos secos.
- Pescados y mariscos[11] [1]
- Legumbres: gran fuente de hierro, especialmente para vegetarianos. Una taza (198 gramos) de lentejas cocidas contiene 6.6 mg, que es el 37% del DV [2]
- Semillas de calabaza.
- Chocolate negro: Una porción de 1 onza (28 gramos) contiene 3,4 mg de hierro.[3]
Alimentos ricos en vitamina C
La vitamina C aumenta significativamente la absorción de hierro:[12]
- Cítricos como el limón y la naranja.
- Verdura como col rizada, pimientos rojos, coles de Bruselas y brócoli.
- Grosella negra, guayaba, perejil, kiwi y papaya.
Véase también
Referencias
- ↑ «Hipocromía». Consultado el 15 de septiembre de 2024.
- ↑ Mean Corpuscular Hemoglobin (MCH) and Mean Corpuscular Hemoglobin Concentration (MCHC): Reference Range, Interpretation, Collection and Panels. 16 de junio de 2021. Consultado el 15 de diciembre de 2021.
- ↑ a b «The Hypochromic Anemias».
- ↑ «Iron deficency anaemia».
- ↑ «Mediline».
- ↑ «medilineplus».
- ↑ «Microcytic anemia: Symptoms, types, and treatment».
- ↑ «Menorragia (sangrado menstrual intenso) - Diagnóstico y tratamiento - Mayo Clinic». www.mayoclinic.org. Consultado el 10 de septiembre de 2018.
- ↑ «Arriba salud».
- ↑ «FoodData Central». fdc.nal.usda.gov. Consultado el 15 de diciembre de 2021.
- ↑ «FoodData Central». fdc.nal.usda.gov. Consultado el 15 de diciembre de 2021.
- ↑ Monsen, E. R. (1988-07). «Iron nutrition and absorption: dietary factors which impact iron bioavailability». Journal of the American Dietetic Association 88 (7): 786-790. ISSN 0002-8223. PMID 3290310. Consultado el 15 de diciembre de 2021.